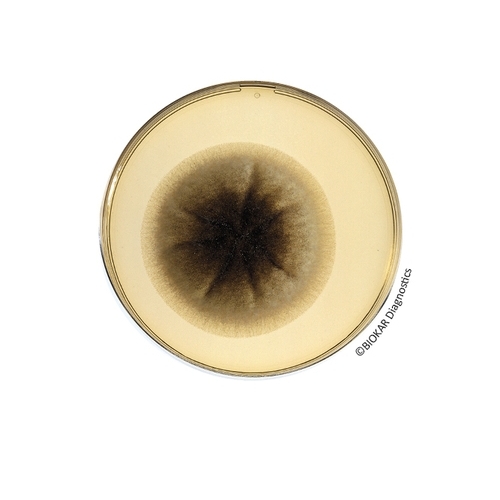
Oxytetracycline Glucose Agar (without Oxytetracycline)

Oxytetracycline Glucose Agar
Oxytetracycline Glucose Agar is used for the detection and enumeration of yeasts and molds in food products
| Ürün Adı | Oxytetracycline 50 mg Selective Supplement |
| Ürün Kodu | BS00808 |
| Miktar | 10 vials |
| Ürün Adı | Oxytetracycline Glucose Agar (without Oxytetracycline) |
| Ürün Kodu | BK053HA |
| Miktar | 500 g |
| Ürün Adı | Oxytetracycline Glucose Agar (without Oxytetracycline) |
| Ürün Kodu | BK053GC |
| Miktar | 5 kg |
| Ürün Adı | Oxytetracycline Glucose Agar (without Oxytetracycline) |
| Ürün Kodu | BM02208 |
| Miktar | 10 vials of 110 mL |